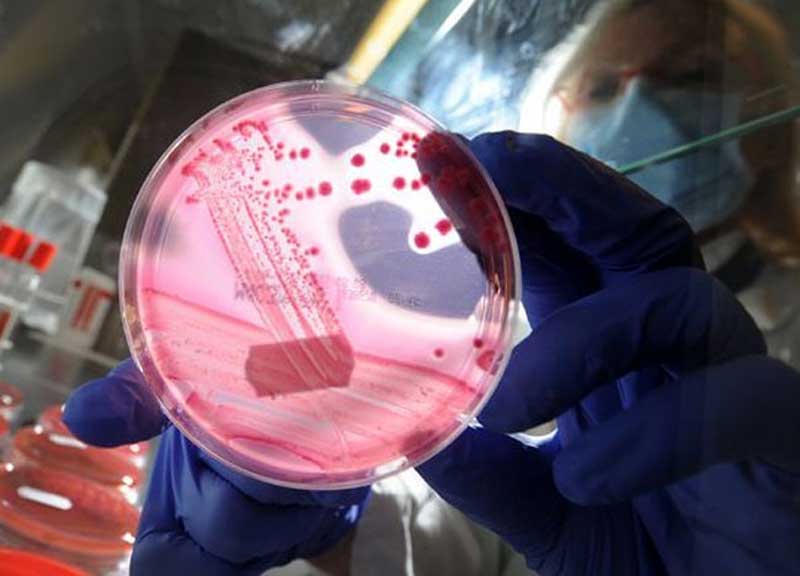
Superbatteri Italia, record di morti per superbatteri resistenti a antibiotici Superbatteri Italia, record di morti per superbatteri resistenti a antibiotici

Antibiotico resistenza, Ue ha il primato per superbatteri resistenti ai farmaci: 33.100 morti, di cui un terzo solo in Italia
L’Italia vanta il primato in Europa per numero di morti da superbatteri resistenti ai farmaci complici mani poco pulite, abuso di antibiotici anche nel mondo animale, troppo turnover di pazienti in ospedali e residenze anziani per i pochi posti letto.
In Ue i super batteri hanno provocato in un anno 33.110 decessi soprattutto fra senior e bimbi nei primi mesi di vita, e un terzo delle vittime – oltre 10 mila – sono state in Italia.
Super batteri e antibiotico resistenza: i numeri, le cause e le possibili soluzioni delle infezioni batteriche
Numeri, cause e possibili soluzioni dell’antibiotico-resistenza, “ormai un’emergenza globale” che nel 2050 porterà le infezioni batteriche al primo posto fra i killer nel pianeta, sono anche al centro del VII Congresso biennale internazionale Amit – Argomenti di malattie infettive e tropicali, in programma a Milano domani e venerdì 14 e 15 marzo. Alla 2 giorni milanese, ospitata dalla Federazione delle Associazioni scientifiche e tecniche-Fast di piazzale Morandi, parteciperanno oltre 300 esperti da tutta Italia e dall’estero. Il primo obiettivo è discutere “le più significative novità nel campo delle malattie infettive, con particolare attenzione alla gestione delle patologie da batteri multi resistenti (Mdr)”.
Superbatteri causa di infezioni: Oms, 500 mila le persone che hanno avuto infezioni da batteri
Il tema dell’emergenza “infezioni da super batteri” è in cima alle agende delle istituzioni di tutto il mondo – dai Cdc negli Usa agli Ecdc e all’Efsa in Europa, dall’Ocse all’Oms i cui dati diffusi in febbraio, seppur parziali e relativi a 22 nazioni, stimano in 500 mila le persone che hanno avuto infezioni da batteri che hanno sviluppato un’antibiotico-resistenza – e tutte hanno elaborato algoritmi e linee guida per la gestione di “numeri sconvolgenti”.
“Attualmente qualunque tipo di infezione, dalle più banali come semplici infezioni cutanee o urinarie, a infezioni gravi quali polmoniti e sepsi, può essere causato da batteri antibiotico-resistenti”, spiega Marco Tinelli, tesoriere della Società italiana di malattie infettive e tropicali, presidente del summit Amit insieme a Massimo Galli, già presidente Simit.
Infezioni da batteri resistenti, i superbatteri che non conoscono confini: chi è più a rischio?
“Sembra un paradosso – continua Marco Tinelli – ma anche una persona che non ha mai preso antibiotici corre il rischio di avere un’infezione da batteri resistenti, soprattutto se si trova in ospedale o nelle altre strutture di assistenza sanitaria. I batteri non conoscono frontiere e le stesse resistenze che si trovano in Europa o negli Stati Uniti si possono evidenziare in villaggi sperduti in Africa e in America Latina, come il report dell’Oms dimostra chiaramente”.
Infezioni da superbatteri in Italia: Istituto superiore di sanità rivela: 9 milioni di ricoveri ogni anno
A livello internazionale, il 63% delle infezioni da superbatteri risulta correlato all’assistenza sanitaria e socio-sanitaria. In Italia, secondo l’Istituto superiore di sanità, su 9 milioni di ricoveri ogni anno si riscontrano da 450 mila a 700 mila casi di infezioni ospedaliere, il 5-8% del totale degenti.
“Nestlé da sempre si impegna ad aiutare genitori ed educatori nel fornire la corretta nutrizione ai bambini – ha affermato Desirée Garofalo, nutrizionista Nestlé – Nutripiatto rientra infatti nel progetto internazionale Nestlé for Healthier Kids, che si pone l’ambizioso obiettivo di aiutare, entro il 2030, 50 milioni di bambini a vivere in modo più sano. E in un Paese come l’Italia, in cui una corretta nutrizione ha come alleato la dieta mediterranea, Nutripiatto ne sostiene ulteriormente i principi, focalizzandosi sulla corretta porzionatura di pasti e alimenti”.